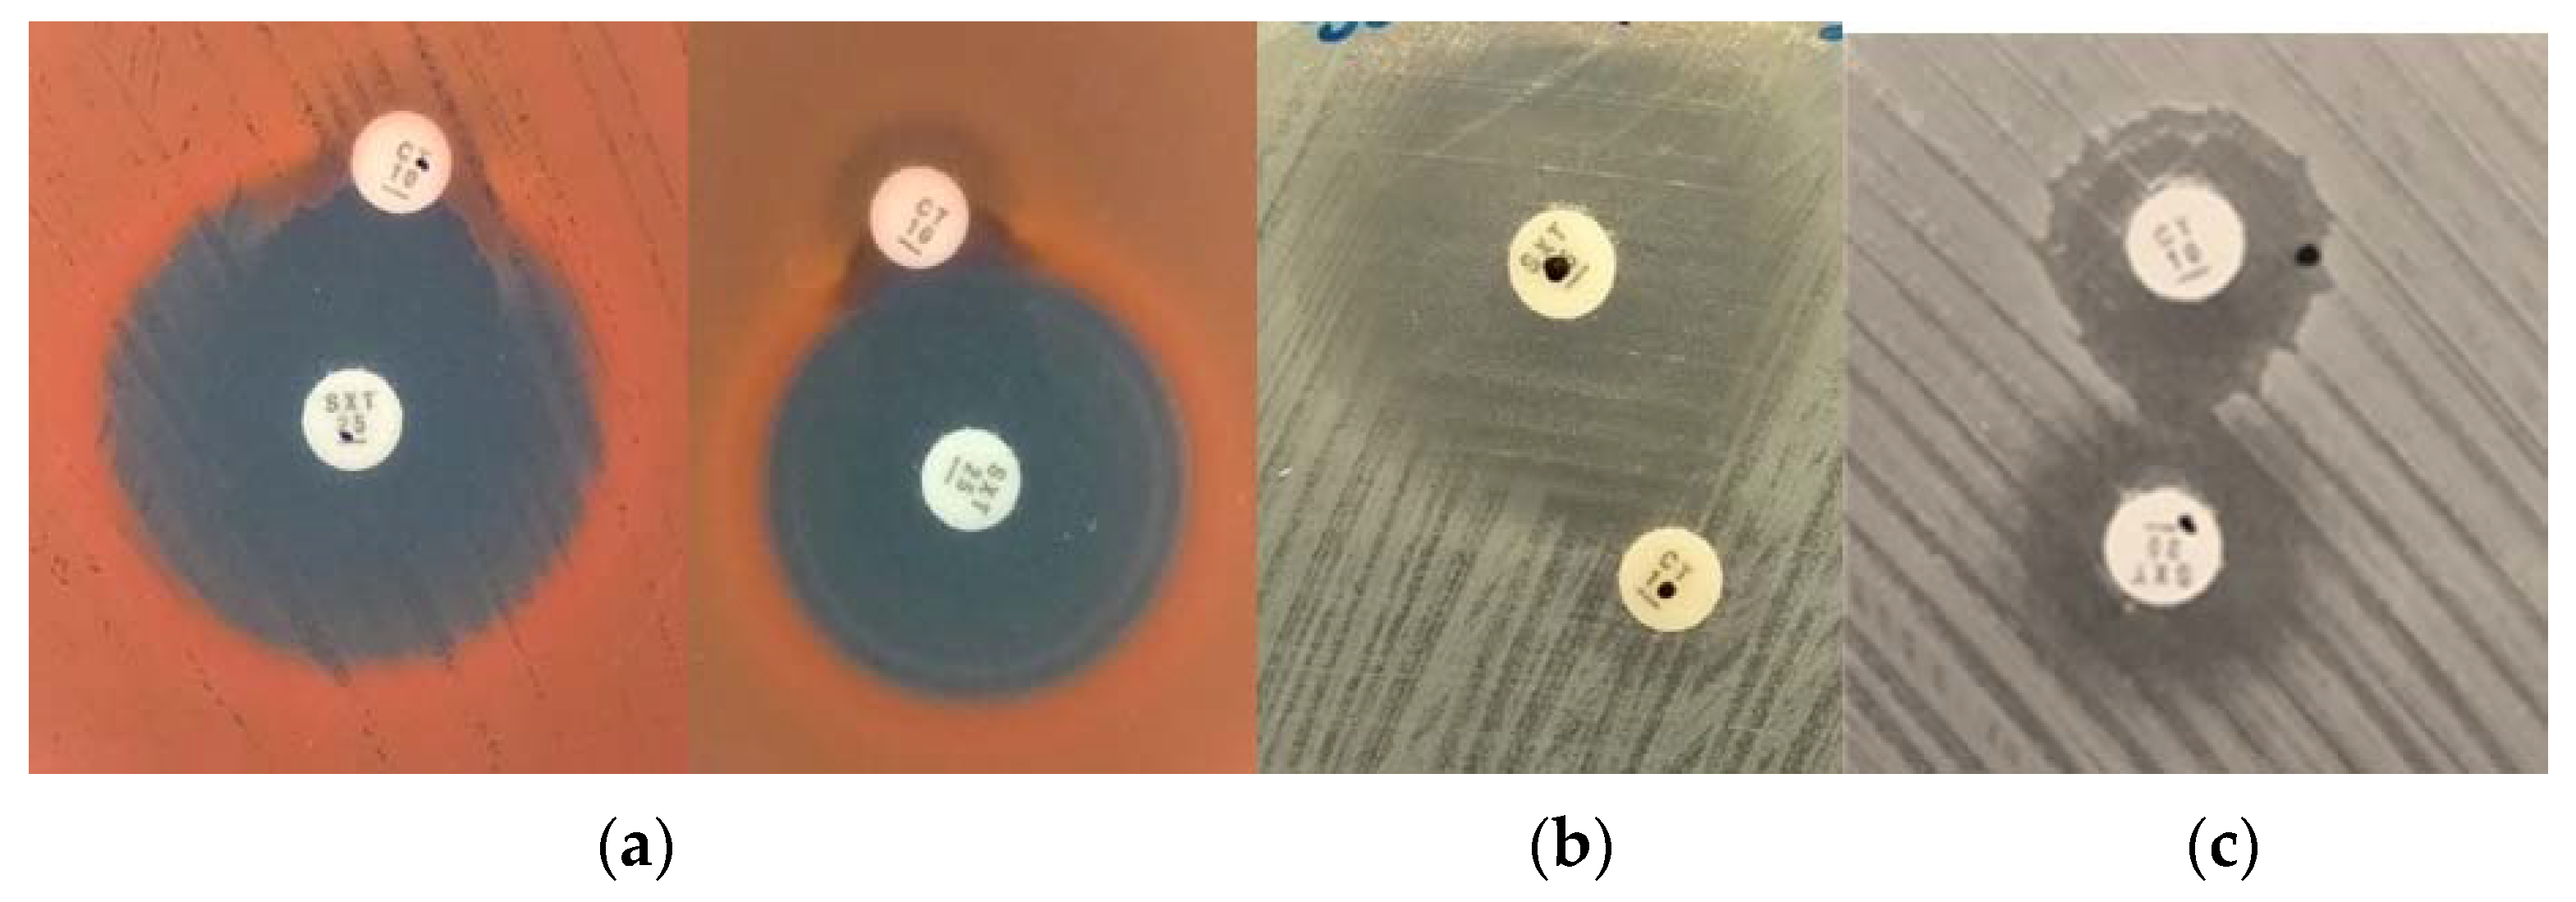
Antibiotics 10 00709 g002 Antibiotics 10 00709 g002

New Trimethoprim-Like Molecules: Bacteriological Evaluation and Insights into Their Action
Abstract
1. Introduction
2. Results and Discussion
2.1. Antimicrobial Susceptibility of Planktonic Bacteria
2.2. Antimicrobial Susceptibility of Sessile Bacteria
2.3. Synergism Studies
2.4. The Role of Efflux Pumps
2.5. Enzymatic Assays
2.6. Cytotoxicity
3. Materials and Methods
3.1. Chemical Synthesis
3.2. Antimicrobial Susceptibility of Planktonic Bacteria
3.3. Antimicrobial Susceptibility of Sessile Bacteria
3.4. Synergism Studies
3.5. Efflux Pumps Effect
3.6. Dihydrofolate Reductase Assay
3.7. Computational Chemistry
3.8. Cytotoxicity
4. Conclusions
Author Contributions
Funding
Institutional Review Board Statement
Informed Consent Statement
Data Availability Statement
Acknowledgments
Conflicts of Interest
References
- Magiorakos, A.P.; Srinivasan, A.; Carey, R.B.; Carmeli, Y.; Falagas, M.E.; Giske, C.G.; Harbarth, S.; Hindler, J.F.; Kahlmeter, G.; Olsson-Liljequist, B.; et al. Multidrug-resistant, extensively drug-resistant and pandrug-resistant bacteria: An international expert proposal for interim standard definitions for acquired resistance. Clin. Microbiol. Infect. 2012, 18, 268–281. [Google Scholar] [CrossRef]
- Toutain, P.L.; Ferran, A.A.; Bousquet-Melou, A.; Pelligand, L.; Lees, P. Veterinary medicine needs new green antimicrobial drugs. Front. Microbiol. 2016, 7, 1196. [Google Scholar] [CrossRef]
- Wright, G.D. Resisting resistance: New chemical strategies for battling superbugs. Chem. Biol. 2000, 7, R127–R132. [Google Scholar] [CrossRef]
- Góngora-Benítez, M.; Tulla-Puche, J.; Albericio, F. Handles for Fmoc solid-phase synthesis of protected peptides. ACS Comb. Sci. 2013, 15, 217–228. [Google Scholar] [CrossRef]
- Deng, J.; Viel, J.H.; Kubyshkin, V.; Budisa, N.; Kuipers, O.P. Conjugation of synthetic polyproline moietes to lipid ii binding fragments of nisin yields active and stable antimicrobials. Front. Microbiol. 2020, 11, 1–9. [Google Scholar] [CrossRef]
- Pedrola, M.; Jorba, M.; Jardas, E.; Jardi, F.; Ghashghaei, O.; Viñas, M.; Lavilla, R. Multicomponent reactions upon the known drug trimethoprim as a source of novel antimicrobial agents. Front. Chem. 2019, 7, 1–9. [Google Scholar] [CrossRef]
- Sans-Serramitjana, E.; Fusté, E.; Martínez-Garriga, B.; Merlos, A.; Pastor, M.; Pedraz, J.L.; Esquisabel, A.; Bachiller, D.; Vinuesa, T.; Viñas, M. Killing effect of nanoencapsulated colistin sulfate on Pseudomonas aeruginosa from cystic fibrosis patients. J. Cyst. Fibros. 2016, 15, 611–618. [Google Scholar] [CrossRef] [PubMed]
- Martin-Gómez, H.; Jorba, M.; Albericio, F.; Viñas, M.; Tulla-Puche, J. Chemical modification of microcin j25 reveals new insights on the stereospecific requirements for antimicrobial activity. Int. J. Mol. Sci. 2019, 20, 5152. [Google Scholar] [CrossRef]
- Schweitzer, B.I.; Dicker, A.P.; Bertino, J.R. Dihydrofolate reductase as a therapeutic target. FASEB J. 1990, 4, 2441–2452. [Google Scholar] [CrossRef]
- Srinivasan, B.; Skolnick, J. Insights into the slow-onset tight-binding inhibition of Escherichia coli dihydrofolate reductase: Detailed mechanistic characterization of pyrrolo [3,2-f] quinazoline-1,3-diamine and its derivatives as novel tight-binding inhibitors. FEBS J. 2015, 282, 1922–1938. [Google Scholar] [CrossRef]
- Raimondi, M.V.; Randazzo, O.; La Franca, M.; Barone, G.; Vignoni, E.; Rossi, D.; Collina, S. DHFR inhibitors: Reading the past for discovering novel anticancer agents. Molecules 2019, 24, 1140. [Google Scholar] [CrossRef]
- Wróbel, A.; Arciszewska, K.; Maliszewski, D.; Drozdowska, D. Trimethoprim and other nonclassical antifolates an excellent template for searching modifications of dihydrofolate reductase enzyme inhibitors. J. Antibiot. 2020, 73, 5–27. [Google Scholar] [CrossRef]
- Costerton, J.W.; Stewart, P.S.; Greenberg, E.P. Bacterial biofilms: A common cause of persistent infections. Science 1999, 284, 1318–1322. [Google Scholar] [CrossRef]
- Hall-Stoodley, L.; Costerton, J.W.; Stoodley, P. Bacterial biofilms: From the natural environment to infectious diseases. Nat. Rev. Microbiol. 2004, 2, 95–108. [Google Scholar] [CrossRef] [PubMed]
- Lauferska, U.; Viñas, M.; Lorén, J.G.; Guinea, J. Enhancement by polymyxin B of proline-induced prodigiosin biosynthesis in non-proliferating cells of Serratia marcescens. Microbiologica 1983, 6, 155–162. [Google Scholar]
- Armengol, E.; Domenech, O.; Fusté, E.; Pérez-Guillén, I.; Borrell, J.H.; Sierra, J.M.; Vinas, M. Efficacy of combinations of colistin with other antimicrobials involves membrane fluidity and efflux machinery. Infect. Drug Resist. 2019, 12, 2031. [Google Scholar] [CrossRef] [PubMed]
- Armengol, E.; Asunción, T.; Viñas, M.; Sierra, J.M. When combined with colistin, an otherwise ineffective rifampicin–linezolid combination becomes active in Escherichia coli, Pseudomonas aeruginosa, and Acinetobacter baumannii. Microorganisms 2020, 8, 86. [Google Scholar] [CrossRef]
- Rudilla, H.; Fusté, E.; Cajal, Y.; Rabanal, F.; Vinuesa, T.; Viñas, M. Synergistic antipseudomonal effects of synthetic peptide AMP38 and carbapenems. Molecules 2016, 21, 1223. [Google Scholar] [CrossRef] [PubMed]
- Fusté, E.; López-Jiménez, L.; Segura, C.; Gainza, E.; Vinuesa, T.; Viñas, M. Carbapenem-resistance mechanisms of multidrug-resistant Pseudomonas aeruginosa. J. Med. Microbiol. 2013, 62, 1317–1325. [Google Scholar] [CrossRef]
- Bennett, B.C.; Wan, Q.; Ahmad, M.F.; Langan, P.; Dealwis, C.G. X-ray structure of the ternary MTX NADPH complex of the anthrax dihydrofolate reductase: A pharmacophore for dual-site inhibitor design. J. Struct. Biol. 2009, 166, 162–171. [Google Scholar] [CrossRef]
- Dias, M.V.B.; Tyrakis, P.; Domingues, R.R.; Leme, A.F.P.; Blundell, T.L. Mycobacterium tuberculosis dihydrofolate reductase reveals two conformational states and a possible low affinity mechanism to antifolate drugs. Structure 2014, 22, 94–103. [Google Scholar] [CrossRef] [PubMed]
- Bystroff, C.; Kraut, J. Crystal structure of unliganded Escherichia coli dihydrofolate reductase. Ligand-induced conformational changes and cooperativity in binding. Biochemistry 1991, 30, 2227–2239. [Google Scholar] [CrossRef] [PubMed]
- Sawaya, M.R.; Kraut, J. Loop and subdomain movements in the mechanism of Escherichia coli dihydrofolate reductase: Crystallographic evidence. Biochemistry 1997, 36, 586–603. [Google Scholar] [CrossRef] [PubMed]
- Vinuesa, T.; Herráez, R.; Oliver, L.; Elizondo, E.; Acarregui, A.; Esquisabel, A.; Pedraz, J.L.; Ventosa, N.; Veciana, J.; Viñas, M. Benznidazole nanoformulates: A chance to improve therapeutics for Chagas disease. Am. J. Trop. Med. Hyg. 2017, 97, 1469–1476. [Google Scholar] [CrossRef] [PubMed]
- EUCAST Reading Guide for Broth Microdilution. Available online: https://www.eucast.org/fileadmin/src/media/PDFs/EUCAST_files/MIC_testing/Reading_guide_BMD_v_3.0_2021.pdf (accessed on 9 April 2021).
- Phetsang, W.; Pelingon, R.; Butler, M.S.; Kc, S.; Pitt, M.E.; Kaeslin, G.; Cooper, M.A.; Blaskovich, M.A.T. Fluorescent Trimethoprim conjugate probes to assess drug accumulation in wild type and mutant Escherichia coli. ACS Infect. Dis. 2016, 2, 688–701. [Google Scholar] [CrossRef] [PubMed]
- Schrödinger Release 2019-2: Glide; Schrödinger LLC: New York, NY, USA, 2019.
- Friesner, R.A.; Banks, J.L.; Murphy, R.B.; Halgren, T.A.; Klicic, J.J.; Mainz, D.T.; Repasky, M.P.; Knoll, E.H.; Shelley, M.; Perry, J.K.; et al. Glide: A New approach for rapid, accurate docking and scoring. 1. Method and assessment of docking accuracy. J. Med. Chem. 2004, 47, 1739–1749. [Google Scholar] [CrossRef] [PubMed]
- Schrödinger Release 2019-3: Maestro; Schrödinger LLC: New York, NY, USA, 2019.
- Schrödinger Release 2016-3: LigPrep; Schrödinger LLC: New York, NY, USA, 2016.
- Friesner, R.A.; Murphy, R.B.; Repasky, M.P.; Frye, L.L.; Greenwood, J.R.; Halgren, T.A.; Sanschagrin, P.C.; Mainz, D.T. Extra precision Glide: Docking and scoring incorporating a model of hydrophobic enclosure for protein-ligand complexes. J. Med. Chem. 2006, 49, 6177–6196. [Google Scholar] [CrossRef] [PubMed]
- The PyMOL Molecular Graphics System; Version 2.0; Schrödinger LLC: New York, NY, USA, 2016.

| MIC (µM) | |||
|---|---|---|---|
| Antimicrobial | E. coli ATCC 25922 | P. aeruginosa PA01 | S. marcescens NIMA |
| TMP | 0.43 | >110.22 | 13.78 |
| TMP (SMX) | 0.11 (2.37) | 13.78 (315.86) | 0.86 (19.74) |
| 1a | 1.25 | >80.10 | 80.10 |
| 1a (SMX) | 0.63 (19.74) | 40.05 (1263.43) | 2.5 (78.96) |
| 1b | 1.02 | >65.50 | 16.37 |
| 1b (SMX) | 0.13 (3.95) | 32.75 (1263.43) | 1.02 (39.48) |
| Colistin | 0.43 | 1.73 | >886.23 |
| Antimicrobial | E. coli ATCC 25922 | S. aureus ATCC 29213 | S. aureus 8124825998 | |||
|---|---|---|---|---|---|---|
| MBEC (μM) | BPC (μM) | MBEC (μM) | BPC (μM) | MBEC (μM) | BPC (μM) | |
| TMP (SMX) | 275.56 (6317.14) | 275.56 (6317.14) | >2204.46 (50,537.15) | 1102.23 (25,268.58) | >2204.46 (50,537.15) | >2204.46 (50,537.15) |
| 1a (SMX) | >1602.06 (50,537.15) | 200.26 (6317.14) | >1602.06 (50,537.15) | 801.03 (25,268.58) | >1602.06 (50,537.15) | >1602.06 (50,537.15) |
| 1b (SMX) | 163.74 (6317.14) | 81.87 (3158.57) | >1309.91 (50,537.15) | 163.74 (6317.14) | >1309.91 (50,537.15) | 327.48 (12,634.29) |
| Strains | FICi |
|---|---|
| E. coli 220560529 | 2.0019 |
| P. aeruginosa SJD536 | 1 |
| P. aeruginosa VH023 | 1 |
| P. aeruginosa SJD481 | 1.003 |
| FICi | |||
|---|---|---|---|
| Antimicrobial | E. coli ATCC 25922 | P. aeruginosa PA01 | S. marcescens NIMA |
| TMP + SMX | 1.02 | 1.25 | 0.13 |
| 1a + SMX | 1.02 | 1.00 | 0.25 |
| 1b + SMX | 1.02 | 1.01 | 0.25 |
| Antimicrobial | MIC (µM) | |
|---|---|---|
| With PAßN | Without PAßN | |
| TMP (SMX) | 1.72 (39.48) | 27.56 (631.71) |
| 1a (SMX) | 5.01 (157.93) | 80.10 (2526.86) |
| 1b (SMX) | 2.05 (78.96) | 32.76 (1263.43) |
| Colistin | 1.73 | 1.73 |
| Compound | Cytotoxicity (%) | |
|---|---|---|
| HepG2 | L-929 | |
| 32 μg/mL | ||
| TMP | 0.35 | 0.8 |
| 1a | ND | 0 |
| 1b | 0.11 | 0 |
Publisher’s Note: MDPI stays neutral with regard to jurisdictional claims in published maps and institutional affiliations. |
© 2021 by the authors. Licensee MDPI, Basel, Switzerland. This article is an open access article distributed under the terms and conditions of the Creative Commons Attribution (CC BY) license (https://creativecommons.org/licenses/by/4.0/).
Share and Cite
Jorba, M.; Pedrola, M.; Ghashghaei, O.; Herráez, R.; Campos-Vicens, L.; Luque, F.J.; Lavilla, R.; Viñas, M. New Trimethoprim-Like Molecules: Bacteriological Evaluation and Insights into Their Action. Antibiotics 2021, 10, 709. https://doi.org/10.3390/antibiotics10060709
Jorba M, Pedrola M, Ghashghaei O, Herráez R, Campos-Vicens L, Luque FJ, Lavilla R, Viñas M. New Trimethoprim-Like Molecules: Bacteriological Evaluation and Insights into Their Action. Antibiotics. 2021; 10(6):709. https://doi.org/10.3390/antibiotics10060709
Chicago/Turabian StyleJorba, Marta, Marina Pedrola, Ouldouz Ghashghaei, Rocío Herráez, Lluis Campos-Vicens, Franciso Javier Luque, Rodolfo Lavilla, and Miguel Viñas. 2021. "New Trimethoprim-Like Molecules: Bacteriological Evaluation and Insights into Their Action" Antibiotics 10, no. 6: 709. https://doi.org/10.3390/antibiotics10060709
APA StyleJorba, M., Pedrola, M., Ghashghaei, O., Herráez, R., Campos-Vicens, L., Luque, F. J., Lavilla, R., & Viñas, M. (2021). New Trimethoprim-Like Molecules: Bacteriological Evaluation and Insights into Their Action. Antibiotics, 10(6), 709. https://doi.org/10.3390/antibiotics10060709

